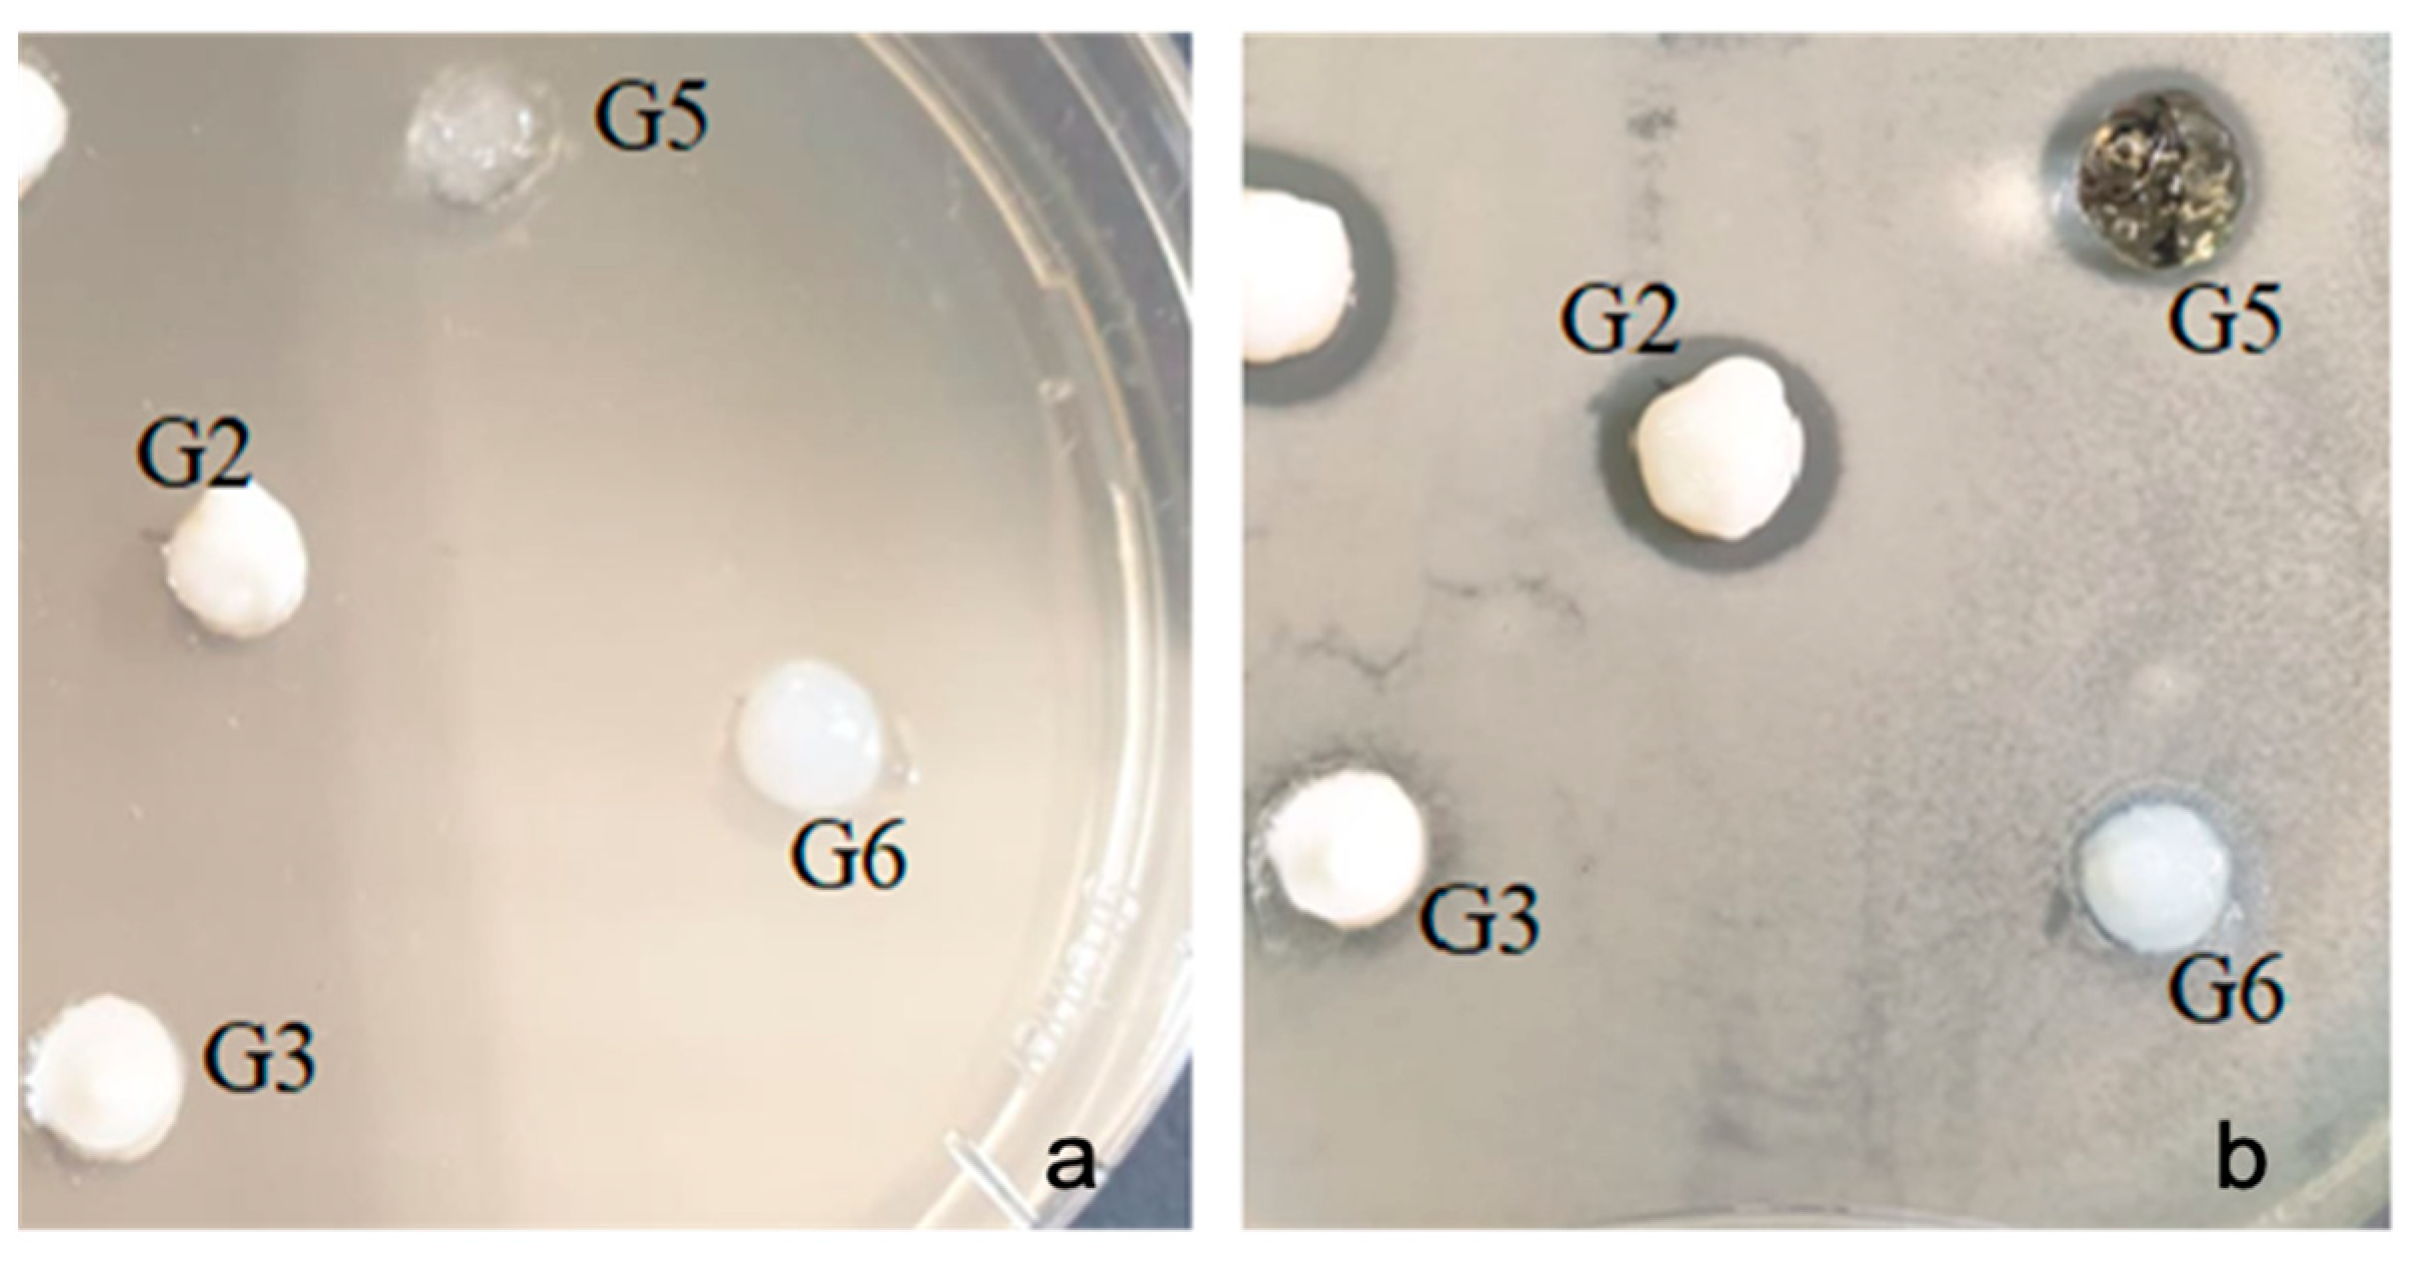
Gels 07 00191 g008 550
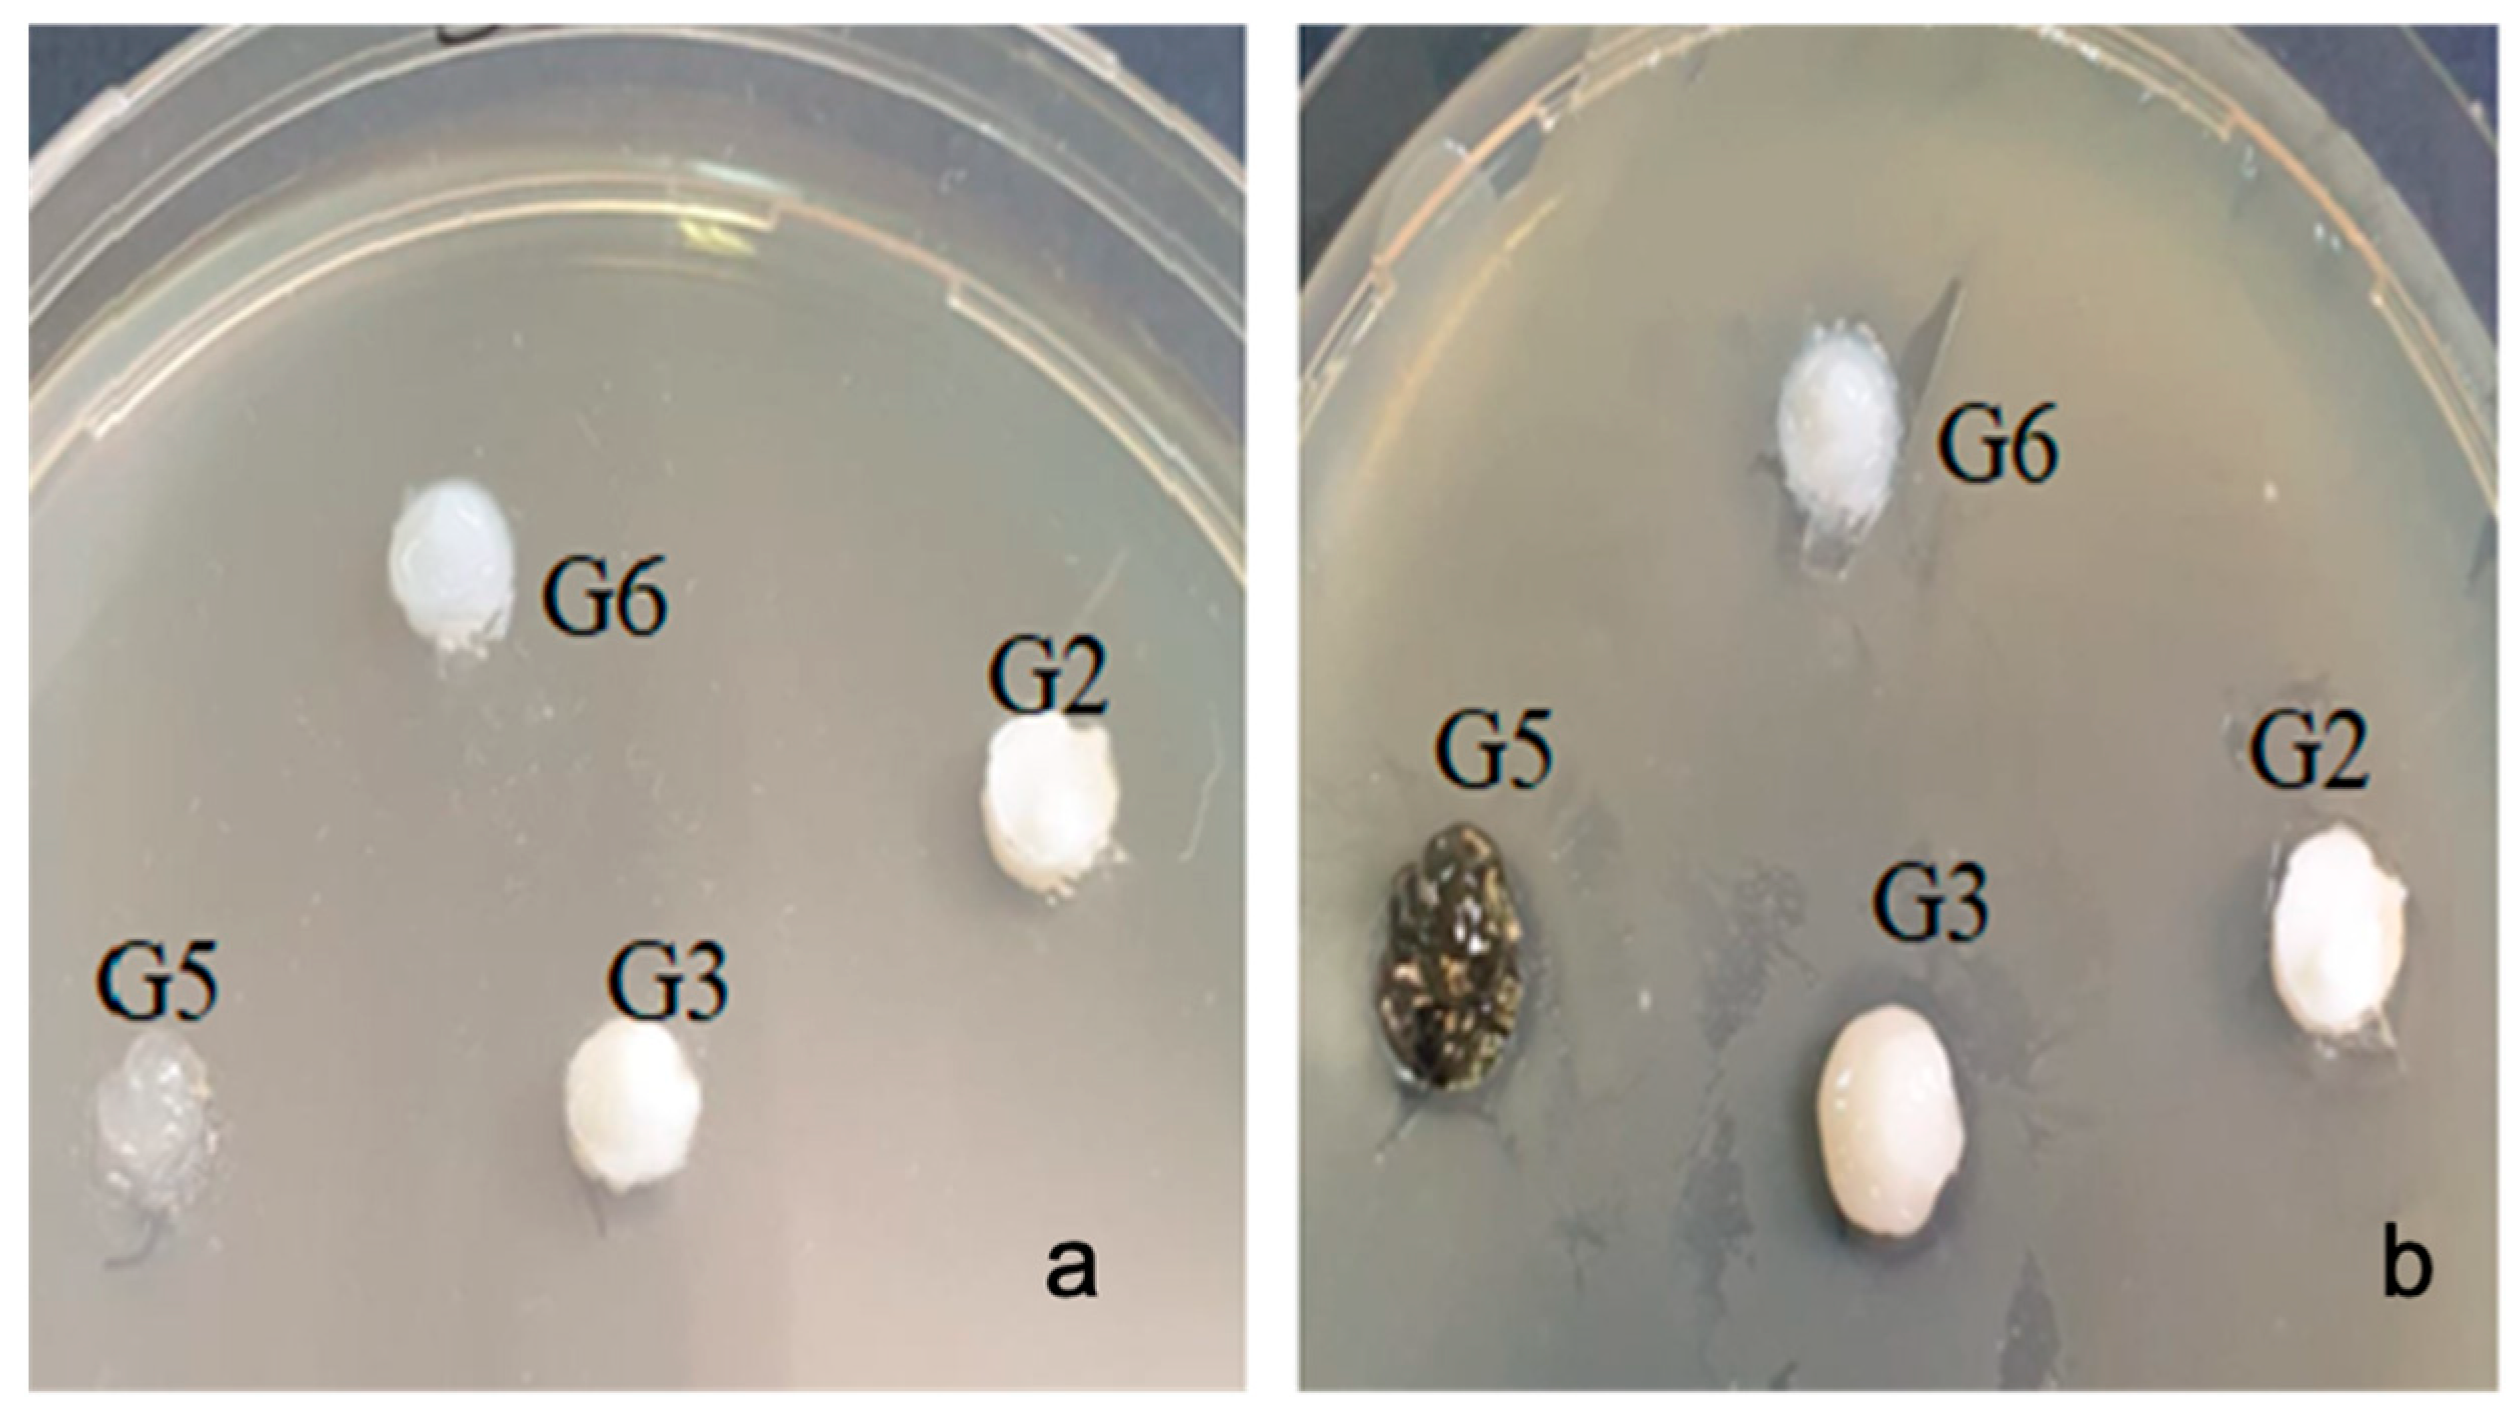
Gels 07 00191 g009 550
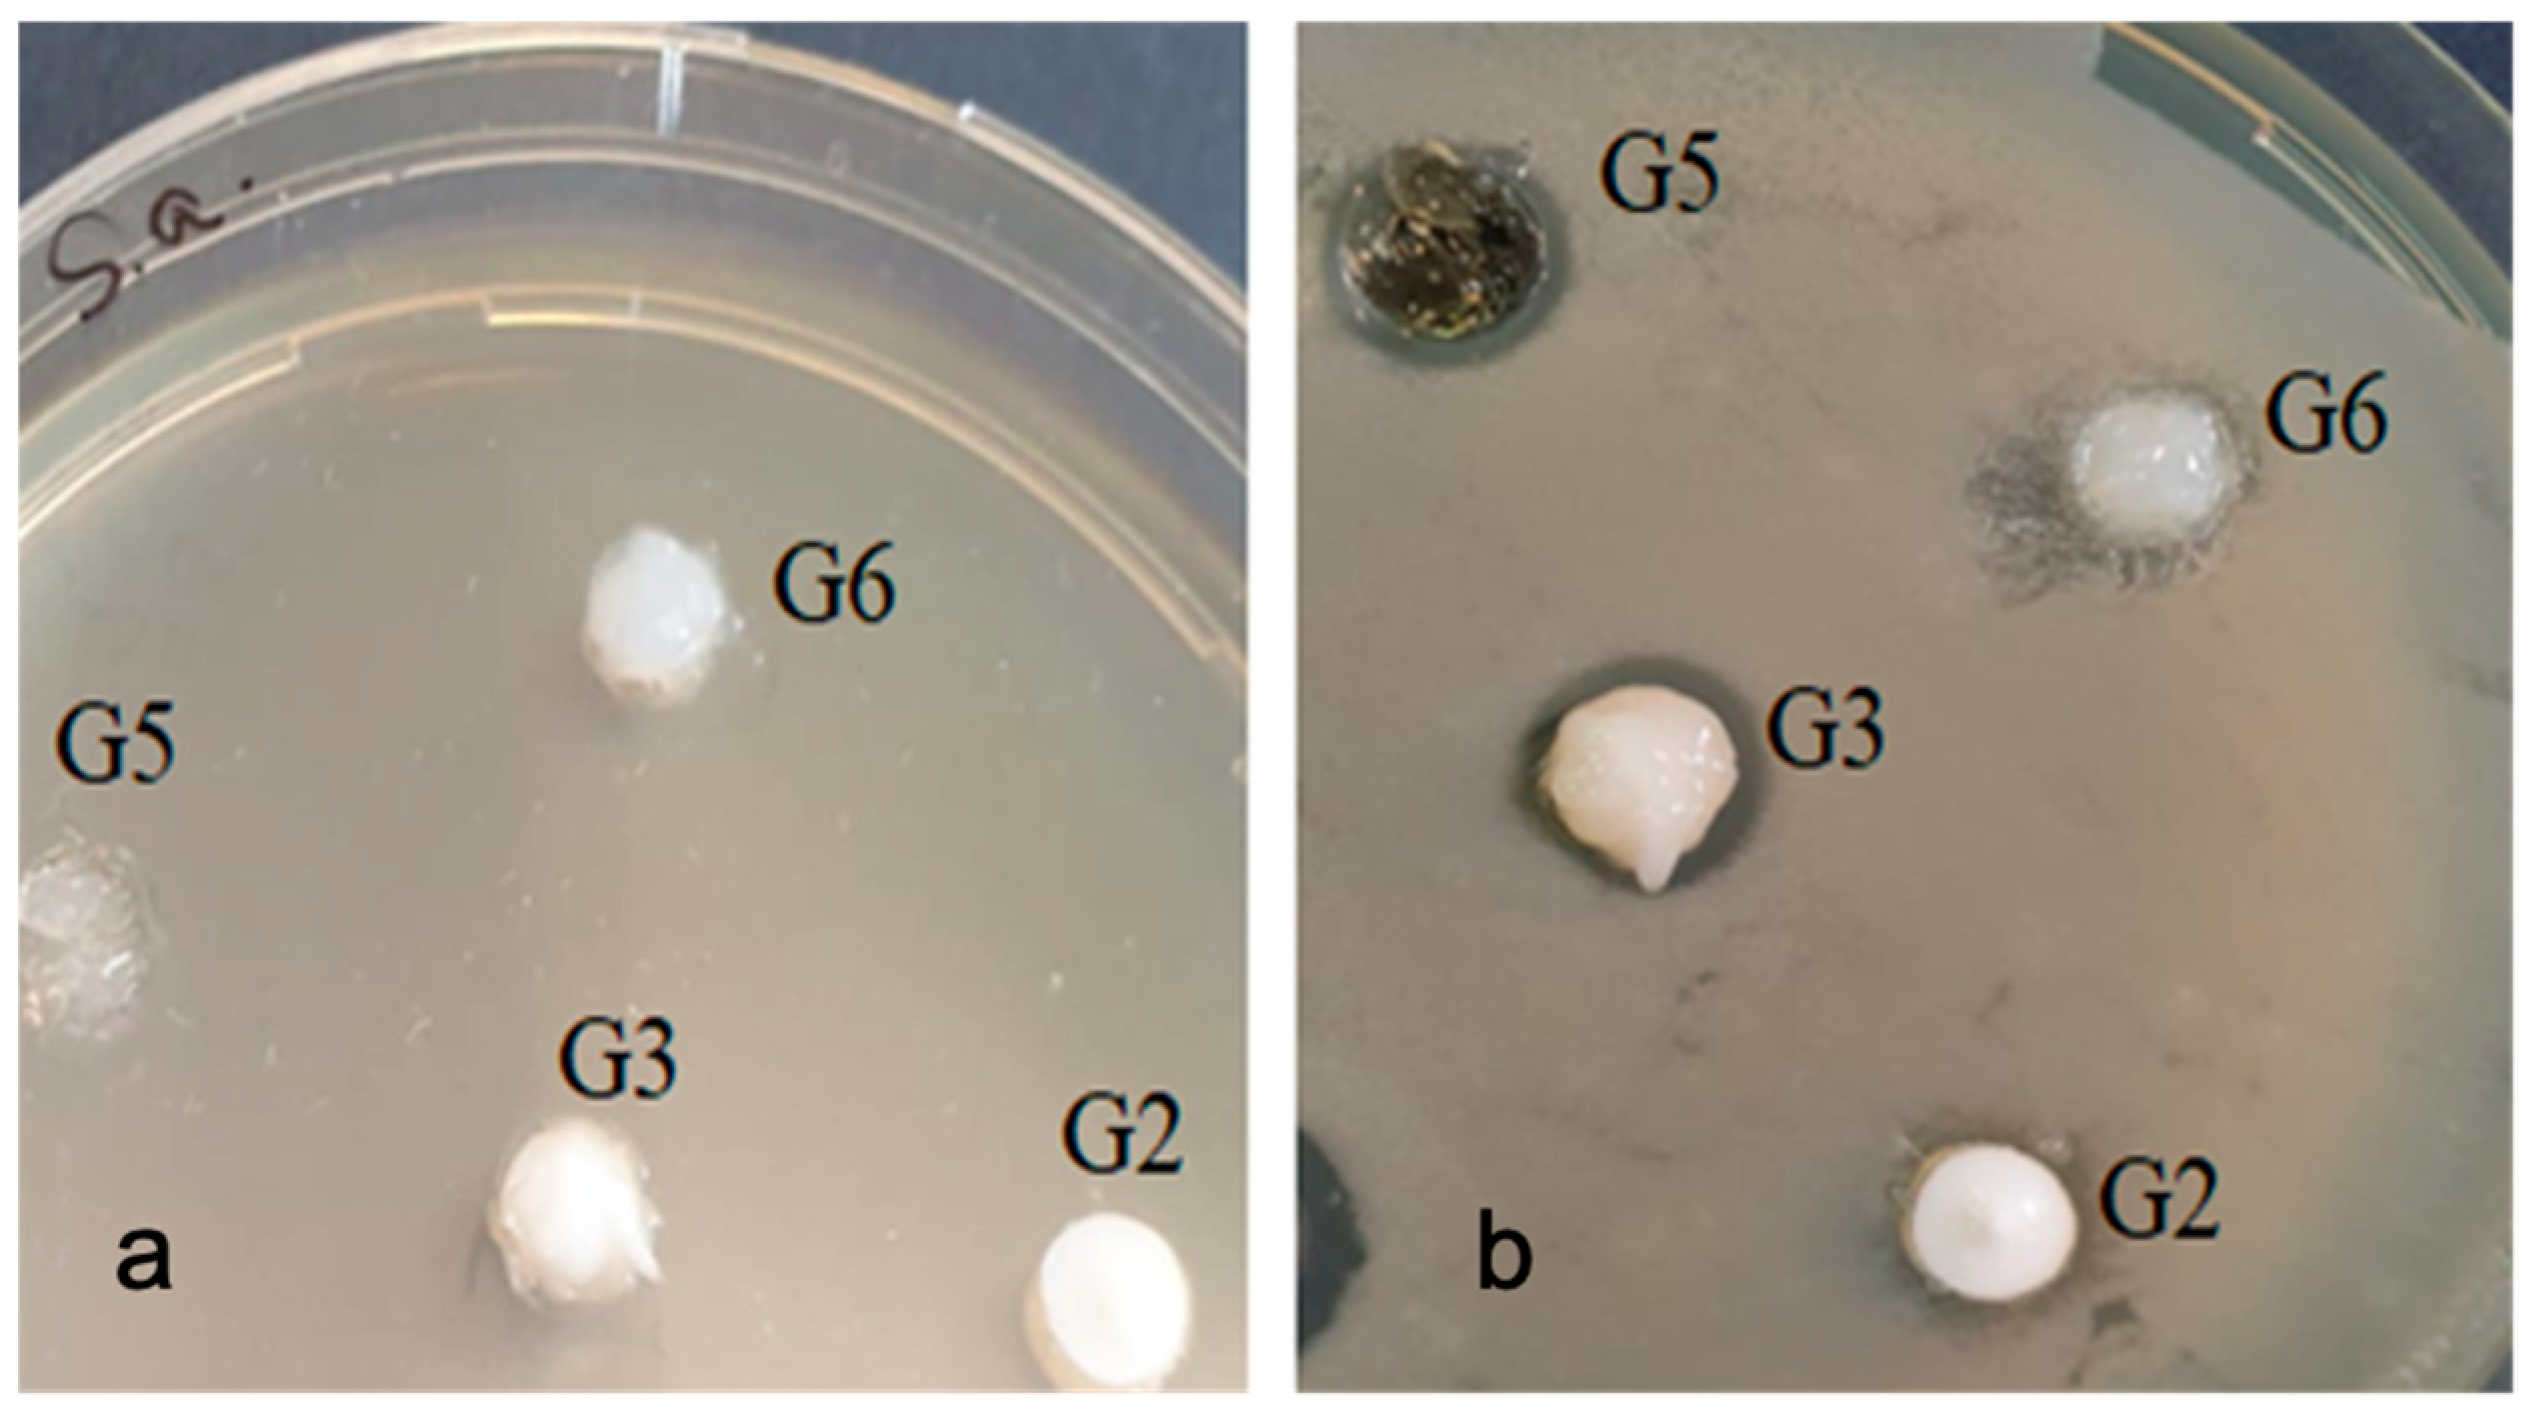
Gels 07 00191 g010 550

Preparation and In Vitro Characterization of Gels Based on Bromelain, Whey and Quince Extract
Abstract
:1. Introduction
2. Results and Discussion
2.1. SDS-PAGE Analysis
2.2. UV-Vis Spectra
2.3. IR Spectra
2.4. SEM Microscopy
2.5. Antimicrobial Testing of Bleaching Gels
3. Conclusions
4. Materials and Methods
4.1. Preparation of Experimental Gels
4.2. SDS-PAGE Analysis
4.3. UV-Vis Spectra
4.4. Infrared Absorption Spectra
4.5. SEM Microscopy
4.6. Antimicrobial Testing of Bleaching Gels
Author Contributions
Funding
Institutional Review Board Statement
Informed Consent Statement
Conflicts of Interest
References
- Oteo Calatayud, J.; Mateos de la Varga, P.; Oteo Calatayud, C.; Calvo Box, M.J. Comparative Clinical Study of Two Tooth Bleaching Protocols with 6% Hydrogen Peroxide. Int. J. Dent. 2009, 2009, 928306. [Google Scholar] [CrossRef] [Green Version]
- Addy, M.; Moran, J. Mechanisms of Stain Formation on Teeth, in Particular Associated with Metal Ions and Antiseptics. Adv. Dent. Res. 1995, 9, 450–456. [Google Scholar] [CrossRef]
- Gheorghe, G.F.; Amza, O.E.; Dimitriu, B.; Garneata, L.; Suciu, I.; Moldovan, M.; Chisnoiu, R.M.; Prodan, D.; Chisnoiu, A.M. Comparative In Vitro Studies on the Effect of Bleaching Agents on Dental Structures in Healthy and Predialysis Patients. Appl. Sci. 2021, 11, 7807. [Google Scholar] [CrossRef]
- Monterubbianesi, R.; Tosco, V.; Bellezze, T.; Giuliani, G.; Özcan, M.; Putignano, A.; Orsini, G. A Comparative Evaluation of Nanohydroxyapatite-Enriched Hydrogen Peroxide Home Bleaching System on Color, Hardness and Microstructure of Dental Enamel. Materials 2021, 14, 3072. [Google Scholar] [CrossRef] [PubMed]
- Schwarzbold, C.G.; Cuevas-Suárez, C.E.; Pacheco, R.R.; Ribeiro, J.S.; Carreño, N.L.V.; Lund, R.G.; Piva, E. In vitro efficacy of commercial and experimental proteolytic enzyme-based whitening dentifrices on enamel whitening and superficial roughness. J. Esthet. Restor. Dent. 2020, 11, 1–7. [Google Scholar] [CrossRef]
- Nipa Tochi, B.; Wang, Z.; Ying Xu, S.; Zhang, W. Therapeutic Application of Pineapple Protease (Bromelain): A Review. Pakistan J. Nutr. 2008, 7, 513–520. [Google Scholar] [CrossRef] [Green Version]
- Gautam, S.S.; Mishra, S.K.; Dash, V.; Goyal, A.K.; Rath, G. Comparative study of extraction, purification and estimation of bromelain from stem and fruit of pineapple plant. Thai J. Pharm. Sci. 2010, 34, 67–76. [Google Scholar]
- Baldea, I.; Olteanu, D.E.; Filip, A.G.; Cenariu, M.; Dudea, D.; Tofan, A.; Alb, C.; Moldovan, M. Toxicity and efficiency study of plant extracts-based bleaching agents. Clin. Oral Investig. 2017, 21, 1315–1326. [Google Scholar] [CrossRef] [PubMed]
- Filip, M.; Moldovan, M.; Vlassa, M.; Sarosi, C.; Cojocaru, I. HPLC Determination of the Main Organic Acids in Teeth Bleaching Gels Prepared with the Natural Fruit Juices. Rev. Chim. 2016, 67, 2440–2445. [Google Scholar]
- Hossain, M.M.; Lee, S.I.; Kim, I.H. Effects of bromelain supplementation on growth performance, nutrient digestibility, blood profiles, faecal microbial shedding, faecal score and faecal noxious gas emission in weanling pigs. Vet. Med. 2021, 60, 544–552. [Google Scholar] [CrossRef] [Green Version]
- Pavan, R.; Jain, S.; Kumar, A. Properties and Therapeutic Application of Bromelain: A Review. Biotechnol. Res. Int. 2012, 2012, 976203. [Google Scholar] [CrossRef] [PubMed] [Green Version]
- Maurer, H.R. Bromelain: Biochemistry, pharmacology and medical use. Cell. Mol. Life Sci. 2001, 58, 1234–1245. [Google Scholar] [CrossRef] [PubMed]
- Larocca, M.; Rossano, R.; Santamaria, M.; Riccio, P. Analysis of pineapple [Ananas comosus (L.) Merr.] fruit proteinases by 2-D zymography and direct identification of the major zymographic spots by mass spectrometry. Food Chem. 2010, 123, 1334–1342. [Google Scholar] [CrossRef]
- Murachi, T.; Yasui, M.; Yasuda, Y. Purification and Physical Characterization of Stem Bromelain. Biochemistry 1964, 3, 48–55. [Google Scholar] [CrossRef]
- Hale, L.P.; Greer, P.K.; Trinh, C.T.; James, C.L. Proteinase activity and stability of natural bromelain preparations. Int. Immunopharmacol. 2005, 5, 783–793. [Google Scholar] [CrossRef]
- Soares, P.A.G.; Vaz, A.F.M.; Correia, M.T.S.; Pessoa, A.; Carneiro-Da-Cunha, M.G. Purification of bromelain from pineapple wastes by ethanol precipitation. Sep. Purif. Technol. 2012, 98, 389–395. [Google Scholar] [CrossRef]
- Ota, S.; Moore, S.; Stein, W.H. Preparation and Chemical Properties of Purified Stem and Fruit Bromelains. Biochemistry 1964, 3, 180–185. [Google Scholar] [CrossRef]
- Babu, B.R.; Rastogi, N.K.; Raghavarao, K.S.M.S. Liquid–liquid extraction of bromelain and polyphenol oxidase using aqueous two-phase system. Chem. Eng. Process Process Intensif. 2008, 47, 83–89. [Google Scholar] [CrossRef]
- Ketnawa, S.; Sai-Ut, S.; Theppakorn, T.; Chaiwut, P.; Rawdkuen, S. Partitioning of bromelain from pineapple peel (Nang Lae cultv.) by aqueous two phase system. Asian J. Food Agro-Ind. 2009, 2, 457–468. [Google Scholar]
- Kalyana, P.; Shashidhar, A.; Meghashyam, B.; SreeVidya, K.; Sweta, S. Stain removal efficacy of a novel dentifrice containing papain and Bromelain extracts–an in vitro study. Int. J. Dent. Hyg. 2011, 9, 229–233. [Google Scholar] [CrossRef] [PubMed]
- Münchow, E.A.; Hamann, H.J.; Carvajal, M.T.; Pinal, R.; Bottino, M.C. Stain removal effect of novel papain- and bromelain-containing gels applied to enamel. Clin. Oral Investig. 2016, 20, 2315–2320. [Google Scholar] [CrossRef]
- Chakravarthy, P.; Acharya, S. Efficacy of Extrinsic Stain Removal by Novel Dentifrice Containing Papain and Bromelain Extracts. J. Young Pharm. 2012, 4, 245. [Google Scholar] [CrossRef] [Green Version]
- Mazilu, A.; Sarosi, C.; Moldovan, M.; Miuta, F.; Prodan, D.; Antoniac, A.; Prejmerean, C.; Silaghi Dumitrescu, L.; Popescu, V.; Raiciu, A.D.; et al. Preparation and Characterization of Natural Bleaching Gels Used in Cosmetic Dentistry. Materials 2019, 12, 2106. [Google Scholar] [CrossRef] [Green Version]
- Silaghi-Dumitrescu, R.; Tomoiaga, N.; Jurco, E. Variability in biochemical composition of milk among three representative breeds of dairy cows from Romania. Stud. Univ. Babes-Bolyai. Chem. 2018, 63, 55–62. [Google Scholar] [CrossRef]
- Popescu, V.; Molea, A.; Moldovan, M.; Lopes, P.M.; Mazilu Moldovan, A.; Popescu, G.L. The Influence of Enzymatic Hydrolysis of Whey Proteins on the Properties of Gelatin-Whey Composite Hydrogels. Materials 2021, 14, 3507. [Google Scholar] [CrossRef] [PubMed]
- Setyawati, A.; Nur, S.N.F.F. The Effectiveness Differences Between Watermelon (Citrullus Lanatus) Extract 100% and Carbamide Peroxide Gel 10% in Tooth Whitening (Ex Vivo). J. Indones. Dent. Assoc. 2020, 3, 31–36. [Google Scholar] [CrossRef]
- Monterubbianesi, R.; Sparabombe, S.; Tosco, V.; Profili, F.; Mascitti, M.; Hosein, A.; Putignano, A.; Orsini, G. Can Desensitizing Toothpastes Also Have an Effect on Gingival Inflammation? A Double-Blind, Three-Treatment Crossover Clinical Trial. IJERPH 2020, 17, 8927. [Google Scholar] [CrossRef] [PubMed]
- Qasim, M.; Ananthaiah, J.; Dhara, S.; Paik, P.; Das, D. Synthesis and Characterization of Ultra-Fine Colloidal Silica Nanoparticles. Adv. Sci. Eng. Med. 2014, 6, 965–973. [Google Scholar] [CrossRef]
- Mobin, M.; Basik, M.; Aslam, J. Pineapple stem extract (Bromelain) as an environmental friendly novel corrosion inhibitor for low carbon steel in 1 M HCl. Measurement 2019, 134, 595–605. [Google Scholar] [CrossRef]
- Mynott, T.L.; Ladhams, A.; Scarmato, P.; Engwerda, C.R. Bromelain, from Pineapple Stems, Proteolytically Blocks Activation of Extracellular Regulated Kinase-2 in T Cells. J. Immunol. 1999, 163, 2568–2575. [Google Scholar]
- Praveen, N.C.; Rajesh, A.; Madan, M.; Chaurasia, V.R.; Hiremath, N.V.; Sharma, A.M. In vitro Evaluation of Antibacterial Efficacy of Pineapple Extract (Bromelain) on Periodontal Pathogens. J. Int. Oral Health 2014, 6, 96. [Google Scholar] [PubMed]
- Jahan, I.; Tona, M.R.; Sharmin, S.; Sayeed, M.A.; Tania, F.Z.; Paul, A.; Chy, M.N.U.; Rakib, A.; Emran, T.B.; Simal-Gandara, J. GC-MS Phytochemical Profiling, Pharmacological Properties, and In Silico Studies of Chukrasia velutina Leaves: A Novel Source for Bioactive Agents. Molecules 2020, 25, 3536. [Google Scholar] [CrossRef] [PubMed]

| Sample | G2 | G3 | G6 | G5 |
|---|---|---|---|---|
| Bacteria | Bromelain Gel | Bromelain Gel | SiO2 Gel | Lubrizol Gel |
| Streptococcus mutans | 0 | 0 | 0 | 11 |
| Porphyromonas gingivalis | 9 | 11 | 0 | 10 |
| Enterococcus faecalis | 8 | 12 | 0 | 11 |
| Escherichia coli | 0 | 9 | 0 | 0 |
| Staphylococcus aureus | 7 | 11 | 0 | 10 |
| Gels/Composition (g/10 g Gel) | PEG400 | SiO2 | Quince Extract | Bromelain | Whey | Nanoencapsulated Bromelain | Lubrizol | H2O |
|---|---|---|---|---|---|---|---|---|
| G1 | 2.216 | 1.222 | 7.042 | 0.2 | - | - | - | - |
| G2 | 2.216 | 1.222 | - | 0.2 | 0.2 | - | - | 6 |
| G3 | - | - | - | 0.2 | 0.5 | - | 1 | 11.5 |
| G4 | - | - | - | - | 0.2 | 2 | 1 | 14 |
| G5 (Carbopol) | - | - | - | - | - | - | 0.25 | 10 |
| G6 (SiO2) | 1.22 | 10 | ||||||
| G7 (Bromelaina) | 0.2 | 10 |
Publisher’s Note: MDPI stays neutral with regard to jurisdictional claims in published maps and institutional affiliations. |
© 2021 by the authors. Licensee MDPI, Basel, Switzerland. This article is an open access article distributed under the terms and conditions of the Creative Commons Attribution (CC BY) license (https://creativecommons.org/licenses/by/4.0/).
Share and Cite
Mazilu, A.; Popescu, V.; Sarosi, C.; Dumitrescu, R.S.; Chisnoiu, A.M.; Moldovan, M.; Dumitrescu, L.S.; Prodan, D.; Carpa, R.; Gheorghe, G.F.; et al. Preparation and In Vitro Characterization of Gels Based on Bromelain, Whey and Quince Extract. Gels 2021, 7, 191. https://doi.org/10.3390/gels7040191
Mazilu A, Popescu V, Sarosi C, Dumitrescu RS, Chisnoiu AM, Moldovan M, Dumitrescu LS, Prodan D, Carpa R, Gheorghe GF, et al. Preparation and In Vitro Characterization of Gels Based on Bromelain, Whey and Quince Extract. Gels. 2021; 7(4):191. https://doi.org/10.3390/gels7040191
Chicago/Turabian StyleMazilu, Amalia, Violeta Popescu, Codruta Sarosi, Radu Silaghi Dumitrescu, Andrea Maria Chisnoiu, Marioara Moldovan, Laura Silaghi Dumitrescu, Doina Prodan, Rahela Carpa, Georgiana Florentina Gheorghe, and et al. 2021. "Preparation and In Vitro Characterization of Gels Based on Bromelain, Whey and Quince Extract" Gels 7, no. 4: 191. https://doi.org/10.3390/gels7040191
APA StyleMazilu, A., Popescu, V., Sarosi, C., Dumitrescu, R. S., Chisnoiu, A. M., Moldovan, M., Dumitrescu, L. S., Prodan, D., Carpa, R., Gheorghe, G. F., & Chisnoiu, R. M. (2021). Preparation and In Vitro Characterization of Gels Based on Bromelain, Whey and Quince Extract. Gels, 7(4), 191. https://doi.org/10.3390/gels7040191

